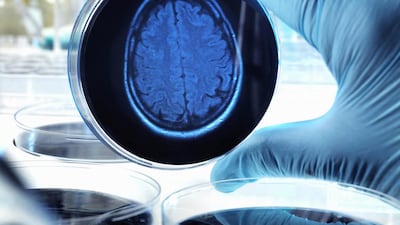
Despite 40 years of research, scientists studying Alzheimer’s don’t know what causes it and do not seem to be any nearer a cure. Getty Images

The global increase in life expectancy is the single most impressive achievement of modern medicine, and the UAE is one of its showcase examples.
Those living here now have a life expectancy in excess of 77 years, a leap of almost 10 per cent since the 1990s – and the second-highest in the region.
But as other nations are discovering, there’s a cruel irony in these statistics, one that will inevitably have an effect on the UAE.
With increasing longevity comes an increasing risk of Alzheimer’s disease.
First identified in 1901 by the German psychiatrist Alois Alzheimer, it is the most common form of dementia and is notorious for robbing people of their memory, personality and ultimately their lives.
Its affects about 50 million worldwide, and cases are set to top 130 million by 2050 as a direct result of the global increase in longevity.
In the US, about one in 10 people aged more than 65 have the disease and the bill for caring for them exceeds $100 billion (Dh367.3bn) .
The scale of the problem in the UAE may be even greater. A 2014 study suggested it may afflict as many as 1 in 7 of those over 60. If so, the economic impact in years to come will be immense.
Speaking at last month’s UAE Innovation Week, Alzheimer’s researcher Prof Taleb Al Tel, of the University of Sharjah, said the disease threatened to put a huge financial burden on the healthcare system.
Patients need constant and expensive care and the impact on families and beyond is huge.
Prof Al Tel also emphasised the most disturbing aspect of this rapidly emerging pandemic. Despite decades of effort and vast sums being spent on research, medical science is still no closer to an effective treatment.
As such, Alzheimer’s is even more worrying than that other dark twist to increased longevity, the growing prevalence of cancer. For while the causes of “the Big C” are well understood, those of Alzheimer’s remain far less clear.
This may come as a shock to anyone familiar with the seemingly endless stream of stories in the media about “breakthroughs” in tackling the disease, and “promising early results” from drug trials.
The sober reality was reflected in a story that made headlines worldwide as Prof Al Tel was delivering his lecture.
US pharmaceutical giant Eli Lilly announced the results of a clinical trial of Solanezumab, a so-called antibody treatment for Alzheimer’s. This had been expected to home in like a guided Alzheimer’s missile on to the sticky protein in the brain that leads healthy cells to wither and die.
Known as amyloid-beta, the protein has been the focus of Alzheimer’s research for decades, and Eli Lilly’s 2,100-patient trial was expected to confirm its central role in the disease.
Previous studies had suggested that Solanezumab might boost the cognitive abilities of patients, and those in Eli Lilly’s trial only had mild cases of Alzheimer’s.
But, as so often before, the patients receiving this latest treatment showed little benefit. The drug has now been abandoned as a treatment and its value in prevention is in doubt.
Yet while Eli Lilly’s share price plunged on the news, it came as little surprise to many veteran Alzheimer’s researchers.
For years, they have warned that the amyloid theory was, to quote one researcher, “a dead horse”.
They include Dr Jack de la Torre, of the University of Texas, in Austin.
In a scathing editorial in the Journal of Alzheimer’s Disease, Dr de la Torre said that despite more than 100,000 clinical and scientific papers having been published in the past 40 years, “there is yet no hope, no effective treatment and no knowledge of what causes this dementia”.
To date, several hundred drugs for Alzheimer’s have been deemed worthy of test in human trials, yet not one has lived up to expectation.
The handful that have shown promise, such as the “breakthrough” drugs Aricept and Tacrine, have proved unable to slow the disease, or have unacceptable side effects.
Critics of the amyloid theory are now calling for researchers to look elsewhere for clues about how to treat the disease.
For more than 20 years, Dr Ruth Itzhaki, of the University of Manchester in England, has advocated the view that amyloid protein was just a symptom of the real cause.
Along with an international team, Dr Itzhaki uncovered evidence Alzheimer’s may actually be triggered by a virus.
They suspect it could be the result of the HSV-1 virus, responsible for cold sores, lying dormant in the body before flaring up again in later life when the disease-fighting immune system is less active.
Studies in mice have shown that those infected with the virus and carrying a gene associated with a higher risk of Alzheimer’s end up with much more amyloid plaque. This suggests that targeting the plaque misses the real culprit, which is left free to wreak havoc.
If correct, the implications are intriguing to say the least. It means we could be vaccinated against Alzheimer’s, while patients with the disease might benefit from treatment with antivirals.
Another new front in the war against Alzheimer’s has been opened up by Dr de la Torre. In his new book, Alzheimer’s Turning Point, he focuses on the fact that almost all the risk factors linked with Alzheimer’s, such as Type 2 diabetes and cardiovascular disease, also affect the flow of blood to the brain.
Again, the idea that blood-starved brain cells may be the real cause of Alzheimer’s opens up new approaches to fighting the disease, including early diagnosis of those at risk and drugs that help to maintain blood flow to the brain as we age.
It’s a thesis that also ties in with growing evidence that we can reduce our risk of Alzheimer’s through keeping mentally and physically fit, and eating a diet rich in vegetables, fruit, olive oil and fish, known to help cut the risk of cardiovascular disease.
It may even explain the failure of promising Alzheimer’s drugs. Injected into the bloodstream, they may simply end up stuck there, unable to reach their target.
While scientists may disagree about the best route forward, there’s no doubt about one issue – the need for more, and more broadly based, research funding.
Even in the US, for every dollar spent on caring for an Alzheimer’s patient, less than a cent is spent on research.
There is one other certainty. Propelled by demographics, the growing prevalence of this terrible disease poses a major threat to all nations, including the UAE.
Robert Matthews is visiting professor of science at Aston University, Birmingham, England.